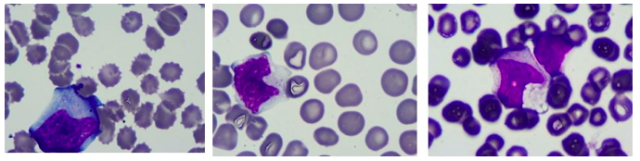
image1.png

患儿女,10 岁,主诉高热伴腹痛 4 天入院。
入院查体:急性病容,体温 38.5℃,呼吸急促,双侧颈部、腋窝、腹股沟可触及肿大淋巴结,最大 1.0×1.5 cm,质软,有压痛感,活动度可;脾大,肋下约 2 cm,质软无压痛,余无明显阳性体征。血常规示:Hb 135 g/L,WBC 19.6×109/L,LYM:78%,PLT 142×109/L。入院后完善骨髓涂片,流式等检查。
涂片结果如下:骨髓增生活跃,原始细胞比例不好,粒细胞比例减低,淋巴细胞比例升高,可见约 14.5% 的异淋(图一)。
图一 异形淋巴细胞
流式结果如下:未见明显异常原始细胞,粒细胞相对比例减低,淋巴细胞相对比例升高,T 细胞 CD4 比 CD8 比值减小(0.21),CD8 阳性的 T 细胞分两群,一群 CD3 和 CD8 较弱(同时 CD7 减弱,CD2 和 CD5 也可以有一定程度减弱),一群 CD3 和 CD8 较强(图二)。

图二 T 细胞免疫表型
同时,该患儿 EBV DNA 定量为 3.4×109/ml,EBV IgM 抗体阳性,最终诊断为传染性单核细胞增多症。
传染性单个核细胞增多症 (infectious mononucleosis IM),简称为传单。传单是由于 EBV 病毒感染导致的一种良性自限性疾病。EBV 病毒是双链 DNA 病毒,属于疱疹病毒疾病都和 EBV 有关系,譬如鼻咽癌,Burkitt 淋巴瘤,噬血细胞综合征等等。3-5 岁幼儿 90% 以上曾经感染 EBV,90% 以上的成人都有病毒抗体(IgG 抗体)。不过大家不用担心,由于我们正常的免疫系统,所以我们只是一过性感染 EBV 而已,并不会对我们造什么大麻烦。
传单多发生在青少年,40 岁以后很少见。典型传单的临床表现是发热,咽喉部疼痛,淋巴结肿大(颈部淋巴结肿大比较常见),另外还有肝脾肿大。血常规往往白细胞升高,并以淋巴细胞升高为主,血涂片可见异型淋巴细胞;部分患儿可出现眼睑浮肿、皮疹等。血常规检查时出现异常淋巴细胞指标上升,扁桃体肿大且其表面上有一层白膜,往往被误认为化脓性扁桃体炎。但需要注意,传单一般不会出现贫血和血小板减少,这是很重要的临床鉴别要点。另外,还有 EBV 感染的 IgM 型抗体及 EBV 的 DNA 定量是必须要检测的。传单最需要鉴别的疾病是:急性淋巴细胞白血病/淋巴母细胞淋巴瘤,此类疾病是儿童及青少年最常见的血液肿瘤,往往血常规有三系异常,通过骨髓穿刺涂片,流式,活检,基因等检测可以明确诊断。
下期预告
妊娠是一个复杂的生理过程。从免疫学角度看, 带有父方抗原的胎儿及其附属物类似半异体移植物, 将导致母体免疫系统对其进行免疫识别及应答。从妊娠结局来看, 又与移植不同, 母体对胎儿的免疫应答发生某种变化, 使胎儿不致被排斥。目前为止,妊娠及分娩过程机理尚不明确. 但可以确定免疫细胞及反应在其中发挥了重要作用。在妊娠期间,机体总的免疫功能状态是如何变化的,哪一群细胞对于监测妊娠和复发性流产等方面有着重要的意义?请在评论区给出您的看法,下期内容更新后我们会在评论中抽取相关评论送出精美礼品来鼓励大家的积极参与。
作者:
周剑峰 博士 金域医学营销运营中心血液疾病医学总监
2002 年-2008 年 医学学士 山东大学医学院临床医学英语班
2008 年-2013 年 临床医学博士(内科学 血液方向)中国医学科学院北京协和医学院天津血液病医院,师从我国著名儿童血液病专家 竺晓凡教授 在研究生期间完成了大内科及大血液内科轮转,具有较扎实的大内科及血液内科基本功,参与了国家自然基因项目及国家科技攀登项目,并在国内外多种期刊发表数篇文章。
2013 年加入金域医学,主要负责血液病理诊断,特别善长于血液肿瘤免疫分型检测,微小残留病流式检测及血液病的分子诊断。